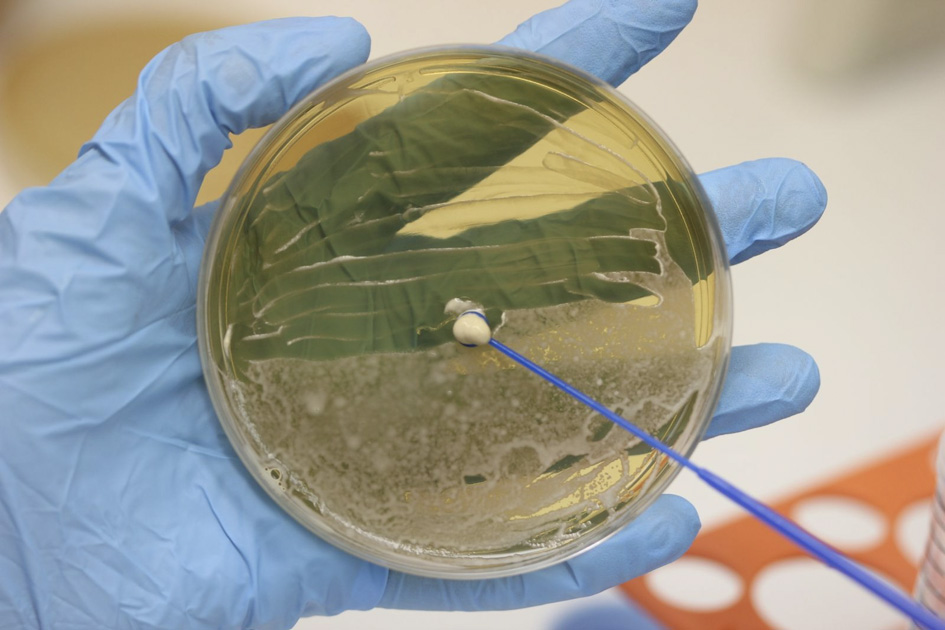
A imagem mostra uma mão com luvas azuis de laboratório segurando uma placa redonda contendo meio de cultura de cor amarelada. Um bastão de inoculação azul toca uma colônia arredondada de cor clara localizada mais ao centro da placa. O ambiente ao redor é claramente laboratorial, com fundo desfocado em tons claros.

Texto: Leonardo Ozima* / Arte: Gustavo Radaelli** / Jornal da USP
Equipe da Faculdade de Odontologia de Ribeirão Preto (Forp) da USP desenvolveu e testou com sucesso uma solução irrigadora à base de probiótico com potencial para substituir com vantagem a solução de irrigação tradicional, feita com hipoclorito de sódio, usada na clínica odontológica.
Na prática, o estudo formulou uma alternativa ao líquido de limpeza e desinfecção do interior do dente (para lavar os canais durante o tratamento) usando a cepa probiótica Bifidobacterium animalis subsp. lactis HN019. Esta cepa de bactéria, também conhecida por HN019, é considerada probiótica pelos benefícios já confirmados à saúde imunológica e intestinal. É a mesma encontrada nos iogurtes e também na microbiota gastrointestinal humana.
A antissepsia é crucial para o sucesso de procedimentos dentários, como os tratamentos de canal que necessitam de soluções de irrigação para chegar até áreas não acessadas por instrumentos mecânicos. O problema é que também existem desvantagens em algumas soluções irrigadoras já utilizadas na odontologia, como o hipoclorito de sódio. Por isso, a comprovação do poder de uma bactéria “do bem” contra a infecção dentária é mais que oportuna.
A inovação de irrigação probiótica usa bactérias contra bactérias. Considerados aliados no combate a patologias, os probióticos são bactérias tidas como ferramentas terapêuticas já que têm propriedades importantes na promoção de saúde e utilizadas em diversas áreas da medicina. Os testes com a nova solução revelaram que, para além de menor toxicidade comparada aos métodos tradicionais, o probiótico foi capaz de tratar as infecções dentárias, reduzindo inflamações e estimulando o reparo dos tecidos.
Segundo Ana Paula Gomes e Moura, pesquisadora do Programa de Pós-Graduação em Odontologia (Odontopediatria) da Forp e uma das responsáveis pelo estudo, “a nova formulação trouxe resultados animadores, graças à capacidade do probiótico em reduzir a formação de armadilhas extracelulares de neutrófilos (NETs) e melhorar a expressão do peptídeo antimicrobiano Cramp”.
As NETs, conta a pesquisadora, são um dos mecanismos de defesa do sistema imune liberadas pelos neutrófilos (um tipo de glóbulo branco de defesa do organismo) e atuam “como armadilhas que capturam e eliminam patógenos, mas quando produzidas em excesso causam danos aos tecidos e agravam a inflamação”.
Ana Paula Gomes e Moura – Foto: Arquivo pessoal
A solução de irrigação à base de probióticos, no entanto, diminuiu a produção de NETs modulando a resposta imunológica para evitar inflamação excessiva. Quanto ao peptídeo Cramp, que integra o sistema imunológico no combate às bactérias e controle das inflamações, a nova formulação aumentou sua produção, o que leva a benefícios durante o processo inflamatório.
Com base nos resultados de seu estudo, Ana Paula Moura afirma que a solução probiótica combate os microrganismos enquanto protege o tecido e evita danos extras, ao contrário do hipoclorito de sódio, que pode ser citotóxico. “O novo produto oferece ainda o bônus de ajudar o próprio corpo a se recuperar, estimulando o reparo da região apical e periapical”, afirma a pesquisadora.
Melhores resultados em apenas uma aplicação

A inovação veio em forma de solução probiótica com uma bactéria benéfica utilizada para combater a inflamação causada por bactérias nocivas à saúde. A escolha da cepa probiótica se deu com base em aprovações de seu uso em estudos anteriores sobre infecções bucais.
A pesquisa foi conduzida em modelo animal – ratos com infecções no dente, situação equivalente às pessoas que possuem lesões no canal dentário. Os experimentos foram conduzidos no laboratório coordenado pela professora Léa Assed, orientadora de Ana Paula, onde foram tratados e acompanhados, por 21 dias, 45 ratos com lesões periapicais (na ponta da raiz do dente) nos molares. Os animais foram divididos em cinco grupos de nove indivíduos e submetidos a tratamentos, de uma a duas sessões, com a solução de irrigação tradicional e com a nova solução probiótica.
O grupo que recebeu irrigação da solução probiótica apenas uma vez apresentou o melhor desempenho geral, demonstrando menores áreas de lesão e menos inflamação, além de menor quantidade de NETs e maior expressão de Cramp.
Maior potencial de tratamento sem toxicidade
Atualmente o principal composto utilizado como solução de irrigação é o hipoclorito de sódio, um agente antimicrobiano poderoso capaz de eliminar o tecido morto e matar as bactérias. Apesar disso, Ana Paula aponta que “esse agente apresenta desvantagens, como a toxicidade aos tecidos vivos, o que pode agravar a inflamação, além de não promover o reparo”.
A nova formulação à base de probióticos apresenta algumas características diferentes quando comparada com as soluções tradicionais. “A proposta de utilizar um material à base de probiótico é oferecer os mesmos benefícios das soluções já consagradas, mas sem desvantagens como a citotoxicidade. Além disso, essa solução probiótica demonstrou potencial para favorecer a reparação tecidual”, explica.
Cultura da bactéria Bifidobacterium animalis subp. lactis HN019 – Foto: Lisa Araújo
Embora os experimentos tenham sido feitos em modelo animal, os resultados do estudo são considerados animadores e criam perspectivas para que a nova solução de irrigação à base de probióticos seja inserida no mercado. “O próximo passo é a realização de estudos clínicos em humanos, com o objetivo de avaliar a segurança, eficácia e aplicabilidade da solução probiótica em tratamentos endodônticos reais, aproximando essa proposta da prática odontológica”, adianta a pesquisadora sobre os novos passos de sua pesquisa.
Mais detalhes do estudo e da formulação do probiótico podem ser conferidos em artigo publicado na edição de maio deste ano da revista Clinical Oral Investigations.
Mais informações: anapaulamoura@usp.br, com a pesquisadora Ana Paula Gomes e Moura
*Estagiário sob supervisão de Rita Stella
**Estagiário sob orientação de Moisés Dorado
The post Tratamento de canal: solução com probiótico reduz inflamação e repara tecidos em ratos appeared first on Giz Brasil.